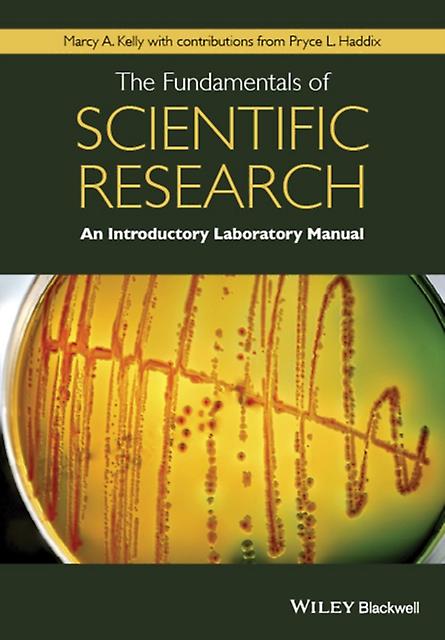

The Fundamentals Of Scientific Research by Marcy A. Kelly Paperback
- 品牌: Unbranded
The Fundamentals Of Scientific Research by Marcy A. Kelly Paperback
- 品牌: Unbranded
| 价格: |
有货
我们接受以下付款方式
描述
- 品牌: Unbranded
- 类别: 杂志
-
语言: English
-
作者: Marcy A. Kelly
-
长度: 208
-
出版日期: 2016-02-26
-
出版社/标签: John Wiley and Sons
-
格式: Paperback
- Fruugo ID: 320467988-711412335
- ISBN: 9781118867846
配送 & 退货
在 24 小时内发货
-
STANDARD: CN¥95.99 - 之间的交付 周四 16 十月 2025–周一 20 十月 2025
从 英国 送货。
我们会争取将您订购的产品按照您的规格完整地配送给您。不过,万一您收到不完整的订单,或收到的产品与您订购的不同,或者有其他原因让您对订单不满意,您可以要求全部或部分退货,您将收到相应产品的全额退款。 查看完整的退货政策
